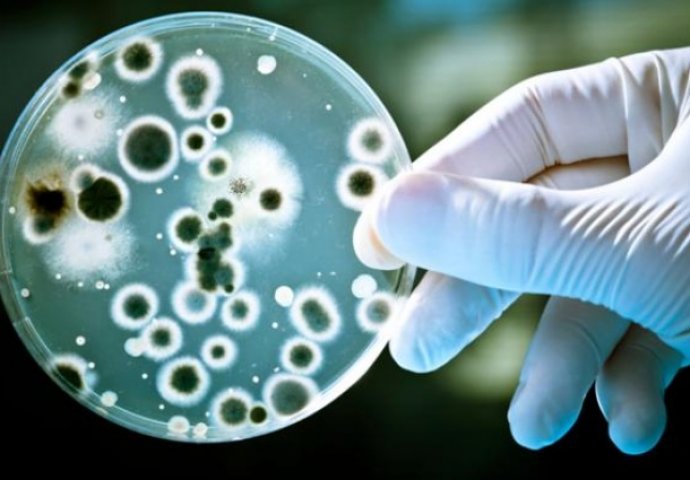
Tìm hiểu Xét nghiệm vi sinh là gì?

Xét nghiệm vi sinh là gì?
Xét nghiệm vi sinh là xét nghiệm để tìm ra nguyên nhân của các bệnh nhiễm trùng. Đối tượng của xét nghiệm này là các vi sinh vật gây bệnh được thu thập từ các bệnh phẩm của người, môi trường sống, thức ăn, các dụng cụ… có liên quan đến nhiễm trùng.
>> Xem thêm: Thông báo tuyển sinh Cao đẳng Xét Nghiệm TPHCM năm 2023
Xét nghiệm vi sinh được chia thành 4 loại là xét nghiệm soi trực tiếp, xét nghiệm nuôi cấy, xét nghiệm miễn dịch và xét nghiệm sinh học phân tử. Trong đó, xét nghiệm soi trực tiếp là bước ban đầu, là cơ sở gợi ý chẩn đoán cho các bước xét nghiệm tiếp theo.
Soi trực tiếp có thể là soi tươi khi các vi sinh vật đang còn sống; soi vi sinh vật qua các loại thuốc nhuộm khác nhau, khi vi sinh vật đã chết; hoặc soi vi sinh vật dưới kính hiển vi điện tử, khi vi sinh vật có kích thước siêu hiển vi (virus).

Xét nghiệm vi sinh học để xác định nguyên nhân bệnh nhiễm trùng
Các bệnh phẩm xét nghiệm vi sinh bao gồm bệnh phẩm nước tiểu giữa dòng, dịch tủy não, dịch (dịch màng phổi, dịch màng tim, dịch khớp…), mủ nông (các nhiễm trùng ngoài da, tổn thương không qua lớp trung bì), mủ sâu (nhiễm trùng kín, tổn thương sâu qua lớp trung bì, dịch dẫn lưu ổ bụng…), chất tiết đường sinh học, ngoáy họng, đờm khạc, dịch ngoáy tỵ hầu, cấy máu, phân…
Ý nghĩa của Xét nghiệm vi học là gì?
Nhiễm trùng là một trong những bệnh có tỉ lệ mắc hàng đầu tại nước ta, cùng với các bệnh không lây nhiễm như tim mạch, tiểu đường, béo phì hay ung thư… Các bệnh nhiễm trùng thường gặp ở đường hô hấp, đường tiêu hóa, đường tiết niệu, đường sinh dục, đường máu, da… Mỗi người đều có thể mắc một đến nhiều lần các căn bệnh này trong cuộc đời. Tuy nhiên, người bệnh lại rất chủ quan, không đến các cơ sở y tế để khám mà tự dùng thuốc kháng sinh để điều trị. Điều này rất nguy hiểm cho sức khỏe về lâu dài, dẫn đến kháng thuốc và suy giảm hệ miễn dịch.
Do đó, việc tìm ra nguyên nhân của các bệnh nhiễm trùng để có hướng điều trị phù hợp là vô cùng cần thiết. Xét nghiệm vi sinh ra đời được xem là phương pháp hữu hiệu giúp các bác sĩ đưa ra phác đồ điều trị đúng nhất cho người bệnh.

Xét nghiệm vi sinh có ý nghĩa vô cùng quan trọng trong điều trị bệnh
>> Đọc thêm: Chương trình đào tạo Cao đẳng Dược chính quy
Giá trị chẩn đoán của soi trực tiếp rất cao và là tiêu chuẩn chẩn đoán vàng trong các trường hợp phát hiện vi khuẩn lao ( AFB, BK), phong ( BH), khi nhuộm kháng cồn kháng toan ( Ziehl – Neelsen), các song cầu khuẩn gram âm trong dịch não tủy là não mô cầu, trong dịch niệu đạo nam giới, dịch dữ mắt ở trẻ sơ sinh, là các vi khuẩn lậu. PGS. TS Lê Văn Phủng, Nguyên Viện trưởng Viện kiểm định vaccine và sinh phẩm y tế nhấn mạnh rằng, tất cả các trường hợp mắc bệnh nhiễm trùng đều phải tiến hành xét nghiệm vi học. Xét nghiệm này đóng vai trò vô cùng quan trọng trong việc chẩn đoán bệnh, từ đó người thầy thuốc mới có thể đưa ra lời khuyên và hướng điều trị tốt nhất cho bệnh nhân và người nhà.
Làm thế nào để đảm bảo chất lượng xét nghiệm vi sinh?
Để đảm bảo tính chính xác, trung thực của mỗi xét nghiệm vi sinh cần thực hiện đồng thời việc đảm bảo chất lượng và kiểm tra chất lượng.
- Đảm bảo chất lượng
Việc đảm bảo chất lượng xét nghiệm vi sinh liên quan đến toàn bộ các hoạt động được lên kế hoạch trong hệ thống quản lý phòng xét nghiệm. Bao gồm: các chính sách, nhân sự, cơ sở hạ tầng, thiết bị, quy trình xét nghiệm, xử lý mẫu, báo cáo kết quả… trong 3 giai đoạn trước, trong và sau xét nghiệm.
- Kiểm tra chất lượng
Kiểm tra chất lượng bao gồm nội kiểm và ngoại kiểm.
Nội kiểm tra chất lượng bao gồm thuốc thử và thuốc nhuộm, môi trường nuôi cấy, kháng nguyên chẩn đoán và kháng nguyên huyết thanh, kháng sinh đồ, PCR, Realtime…
Ngoại kiểm tra chất lượng gồm hình thức kiểm tra lại, phân tích lại, phòng xét nghiệm tham chiếu, hình thức thử nghiệm độ thành thạo, lưu giữ chủng…
Người bệnh nhiễm trùng không nên chủ quan mà cần đến các cơ sở y tế xét nghiệm vi sinh để có hướng điều trị tốt nhất. Tuyệt đối không tự tiện dùng kháng sinh để chữa bệnh tại nhà.
Theo Trường Cao đẳng Y dược Sài Gòn tổng hợp

 096.152.9898 - 093.851.9898
096.152.9898 - 093.851.9898
Giới thiệu các cuốn sách chuyên ngành Xét nghiệm được nhiều người chọn đọc
Giới thiệu các cuốn sách chuyên ngành Xét nghiệm được nhiều người chọn đọc
 Ngành Xét nghiệm Y học là gì? Các chuyên ngành Xét nghiệm Y học
Ngành Xét nghiệm Y học là gì? Các chuyên ngành Xét nghiệm Y học
 Cách tạo mẫu CV xin việc ngành Xét nghiệm Y học tạo ấn tượng
Cách tạo mẫu CV xin việc ngành Xét nghiệm Y học tạo ấn tượng
 Tất Tần Tật Review Ngành Kỹ Thuật Xét Nghiệm Y Học
Tất Tần Tật Review Ngành Kỹ Thuật Xét Nghiệm Y Học
 Chương trình đào tạo ngành Xét nghiệm y học
Chương trình đào tạo ngành Xét nghiệm y học
 Top các trường xét học bạ ngành Xét nghiệm uy tín, chất lượng cao?
Top các trường xét học bạ ngành Xét nghiệm uy tín, chất lượng cao?
 Trường Cao đẳng Y Dược Sài Gòn trao tặng bằng khen cho các tập thể, cá nhân có thành tích xuất sắc trong công tác phòng, chống dịch Covid – 19
Trường Cao đẳng Y Dược Sài Gòn trao tặng bằng khen cho các tập thể, cá nhân có thành tích xuất sắc trong công tác phòng, chống dịch Covid – 19 





 – Cơ sở 1:
– Cơ sở 1:  Email:
Email:  Điện thoại: 0287.1060.222 – 096.152.9898 – 093.851.9898
Điện thoại: 0287.1060.222 – 096.152.9898 – 093.851.9898




